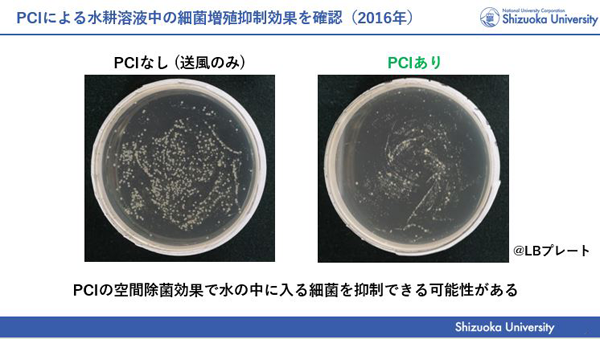

プラズマクラスター技術が寄与する植物の生育促進メカニズムについて発表しました
3月21日(木)、プラズマクラスター技術が寄与する植物の生育促進メカニズムについてのメディア向け発表会を八尾事業所で開催し、オンラインでも配信しました。
最初に、SAS事業本部 プラズマクラスター・ヘルスケア事業部 副事業部長の岡嶋さんより今回の効果検証に至った経緯を紹介。プラズマクラスター技術の社会課題に対する新たな可能性を追求する中で、食料安定供給の課題とその対応策に着目し、「人」だけではなく、「植物」に対してもプラスの効果をもたらすことができないかと考え、実証に取り組んできたことを紹介。 2016 年にレタスの生育促進効果を実証したものの、植物の内部で何が起きていたのかが不明であり、今回、そのメカニズムを解明するため、全遺伝情報が明らかとなっている「イネ」を用いて検証したことを説明しました。
続いて、共同研究を行った静岡大学 農学部の一家崇志准教授より、今回の検証内容についてご説明をいただきました。今回は、種子の発芽以降の初期生育において検証を実施し、遺伝子解析の結果、プラズマクラスターを照射することで、種の中の養分を分解しエネルギー生成を指示する働きが最大約 3倍増加すること、 その結果として、 発芽した芽が最大約 4 倍伸長することを紹介いただきました。
また、検証結果について、「プラズマクラスターイオンの照射が初期生育を促進しているというメカニズムの一端が分かったことは、今後のさまざまな作物に対する研究に応用できる」、「 発芽から育苗までの期間にプラズマクラスターイオンを用いることで、栽培期間を短縮し生産コストを下げるなど、実際の作物栽培にも応用展開できる」などのコメントを頂きました。
最後に、岡嶋さんより今回の検証意義について、「作物の安定供給に繋がる植物工場などに、プラズマクラスター技術が導入される可能性が広がる」と強調した上で、引き続きプラズマクラスター技術による社会課題解決を追求していくことを表明しました。



■プラズマクラスターイオンによる植物生育促進メカニズムの検証試験の概要
当社は今回、「プラズマクラスター技術が寄与する植物の生育促進メカニズム」を 初めて確認することができました。

これまで、先行して、レタスなどの様々な植物でプラズマクラスターイオンによる生育促進効果を確認してきました。

しかし、依然として、プラズマクラスターイオンによる植物の生育促進がどのように誘導されているのかは、明らかにできていませんでした。
今回の研究では、全遺伝情報が明らかにされているモデル植物「イネ」を用いて、植物側の反応を検証しました。
●試験実施者:一家崇志 准教授、山下寛人 助教、石黒雄大 修士課程2年(静岡大学農学部)
●試験場所:静岡大学農学部 実験室 ※分析協力:静岡大学食品分析室
●試験装置:プラズマクラスター技術搭載試験装置
●試験条件:a.プラズマクラスターイオンなし(送風のみ)
b.プラズマクラスターイオンあり
●プラズマクラスターイオン濃度:約1,000,000個/cm3
●試験方法:
・イネの種子(品種:日本晴)を試験装置内の水面上に浮かべた網の上に播種する。
・「送風のみ」と「プラズマクラスターイオンあり」で、所定の日数を栽培する。
・芽の長さと、胚(成長して根や葉になる部分)にある遺伝子の発現量を測定。
遺伝子の発現量は次の4種類についてqRT-PCR法*で測定:Amy、PK、PDC、ADH **
* qRT-PCR法:遺伝子が発現したときに作られる産物を定量測定して、遺伝子の発現量を調べる手法。
** Amy:アミラーゼ遺伝子OsAmy3D PK:ピルビン酸キナーゼ遺伝子OsPK1
PDC:ピルビン酸脱炭酸酵素遺伝子OsPDC2 ADH:アルコール脱水素酵素遺伝子OsADH1




今回の検証により、プラズマクラスターイオン照射によって、エネルギー代謝活性化が誘導され、それに伴う発芽促進ならびに初期生育促進が引き起こされることがわかりました。
■今回の検証意義
1つ目は、作物の安定供給に繋がる植物工場のような露地以外の栽培施設へプラズマクラスター技術導入の可能性が期待できることです。
2つ目は、プラズマクラスター技術が初期以降の生育過程に おいても効果が期待できることです。

当社は引き続き、プラズマクラスター技術が、人の周りにある「空気」だけでなく、そこにいる「人」や「植物」への効果についても実証を進めて参ります。また「社会課題」に対する更なるプラズマクラスター技術の新しい可能性も追求して参ります。


<関連リンク>
・ニュースリリース
プラズマクラスター技術が寄与する植物の生育促進メカニズムを確認
(英文)
Plant Growth Acceleration Mechanism to Which Plasmacluster Technology Contribution Has Been Verified

